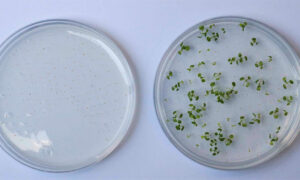
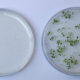

Pune, India, 5 de junio de 2023. – Sistema.bio, la empresa social mexicana y líder mundial de biogás para pequeños productores, celebró el Día Mundial del Medio Ambiente 2023 con la inauguración de la mayor planta de fabricación de biodigestores del mundo en Pune, India. Este logro pionero se alinea con el ambicioso objetivo de la empresa de reducir el 1% de las emisiones mundiales de gases de efecto invernadero (GEI) para 2030. Con una impresionante superficie de 40,00 metros cuadrados (130,000 pies cuadrados), la planta tiene una capacidad de producción anual de 100,000 biodigestores, que repercutirán en la vida de 600, 000 agricultores y capturarán hasta 1 millón de toneladas de CO2e al año.
Con una importante inversión de 1,8 millones de dólares, esta instalación de última generación está preparada para satisfacer la creciente demanda de acceso a la energía y soluciones de fertilización entre los pequeños productores de las regiones de Asia-Pacífico, África Subsahariana y América Latina, donde Sistema.bio opera en 31 países. Los avances en la tecnología del biogás y el aumento de la capacidad de producción desempeñarán un papel fundamental para alcanzar los Objetivos de Desarrollo Sostenible, la promoción de la conservación del medio ambiente y la aceleración de la transición hacia una agricultura descarbonizada.
Esta nueva instalación se suma a la fábrica de Sistema.bio en Toluca, México, la primera planta de producción de la empresa, la cual continúa siendo el centro de suministro para México, América Central, América del Sur y recientemente Estados Unidos. Esta planta, con certificación ISO 9001 vigente desde el 2019, ha implementado nuevos procesos que le permiten duplicar la producción diaria de biodigestores.
Al respecto, Almendra Ortíz Tirado, directora para América Latina de Sistema.bio, reconoció: “Sistema.bio comenzó en México, aquí fue el laboratorio donde se gestó la tecnología y la empresa. Nos sentimos muy orgullosos de la nueva fábrica en India que no sólo aumentará el impacto en esa región del mundo, si no que también permitirá a Sistema.bio seguir innovando, fortalecer nuestra presencia en el mercado latinoamericano, buscar nuevas oportunidades de expansión a otros países de la región y, lo más importante, ofrecer soluciones de la más alta calidad y con la mejor tecnología a través del uso del biogás y biofertilizante que nuestra tecnología genera”.
Con una capacidad diaria de 360 unidades, la fábrica tiene previsto duplicar su producción mediante la automatización de procesos. En comparación con las 30,000 unidades de producción de la planta anterior, la capacidad anual de esta nueva fábrica, de 100,000 unidades, supone un importante salto adelante. Las instalaciones han obtenido la certificación ISO 9001, que garantiza la entrega de productos de alta calidad.
En la inauguración, Camilo Pages, cofundador y CPO de Sistema.bio, comentó: «Hoy celebramos la apertura de la fábrica de biodigestores más grande del mundo, no sólo por el notable logro de ingeniería y trabajo en equipo que representa, sino también por el potencial que tiene para mejorar la vida de los pequeños agricultores de todo el mundo. Estamos orgullosos de formar parte de un movimiento que valora la sostenibilidad, la innovación y la responsabilidad social, y nos motiva a seguir trabajando para crear un mundo más equitativo en el que todos los agricultores tengan acceso a las herramientas y los recursos que necesitan para prosperar.»
La puesta en marcha de la mayor planta de fabricación de biodigestores del mundo marca un hito importante en el panorama de la energía sostenible. Esta instalación sin precedentes revolucionará la industria del biogás, permitiendo a Sistema.bio satisfacer la creciente demanda de soluciones de energía limpia entre los agricultores de todo el mundo. Sistema.bio, empresa orgullosamente mexicana, celebra la oportunidad que esta nueva planta ofrece para llevar su tecnología a distintos países y beneficiar al mayor número de familias.